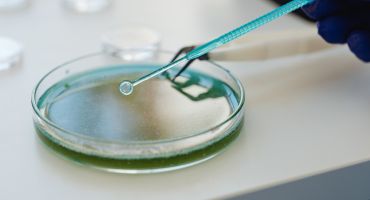
מחקר יזם ומחקר חוקר יזם

ועדת הלסינקי
ברוכים הבאים,
המרכז הרפואי שמיר (אסף הרופא) מקדם מחקרים קליניים כחלק בלתי נפרד מהעשייה הרפואית והמדעית.
וועדת הלסינקי במרכזינו היא וועדת האתיקה האחראית על כל הקשור לביצוע מחקרים.
תפקידה לבחון את כלל המחקרים בהיבטים של אתיקה, בטיחות המטופל, ואיכות אקדמית.
"החזון שלנו:
קידום מחקר רפואי אתי, מקצועי ומבוקר המכוון לבריאות ולרווחת המטופל ולשיפור בריאות הציבור.
תפקידה המרכזי של הוועדה הוא לוודא כי כל מחקר עומד בתקנות האתיקה והחקיקיה בישראל תוך הגנה על זכויות המשתתפים."
- מהו מחקר קליני?
- למה להשתתף במחקר קליני?
- פעילות המחקר בבית החולים
- "מחקר בנתונים קיימים ושאלונים"
- "ניסוי רפואי / מחקר רפואי / ניסוי קליני"
- "ניסוי רפואי לא התערבותי"
- הצהרת הלסינקי – תקציר
- מובילים ברפואה – עם יחס אישי
מהו מחקר קליני?
מחקר קליני הוא מחקר מדעי שמבצוע בבני אדם, במטרה להעריך את הבטיחות והיעילות של טיפול רפואי, תרופה, חיסון, מכשור רפואי, או שיטת אבחון/מניעה.
למה להשתתף במחקר קליני?
ישנם מגוון יתרונות להשתתפות במחקר קליני
היתרונות כוללים:
- קבלת טיפול ע"י צוות מקצועי הנמצא בחזית קידמת הרפואה.
- ליווי רפואי צמוד ומעקב קפדני עבור משתתף המחקר.
- מתן גישה לטיפולים חדשניים ולעיתים כאלו שטרם זמינים לציבור הרחב.
- סיכוי להצלחת הטיפול עבור המשתתפים.
- תרומה אישית לקידום הרפואה והמדע.
פעילות המחקר בבית החולים
מעל 750 מחקרים פעילים.
מחקרים במגוון רחב של תחומים רפואיים: אונקולוגיה, קרדיולוגיה, גניקולוגיה, נוירולוגיה, גסטרואנטרולוגיה, המקצועות הכירורגיים רפואת ילדים ועוד.
כ -25 מחלקות ויחידות רפואיות משתתפות באופן פעיל במחקרים קליניים.
שיתופי פעולה עם אוניברסיטאות, חברות תרופות, מכוני מחקר וגורמים בינלאומיים.
"מחקר בנתונים קיימים ושאלונים"
מחקר במידע בריאותי, ובלבד שהמחקר אינו כרוך בביצוע הליך, פעולה, או בדיקה גופנית, או במתן תרופה, קרינה, חומר כימי, ביולוגי, רדיולוגי או פרמקולוגי למשתתף.
קיימים שני סוגים:
א- מחקר פרוספקטיבי שבו נאסף מידע בריאות מבני אדם תוך יצירת קשר עמם.
ב- מחקר רטרוספקטיבי במידע בריאות, בו נאסף מידע מרשומות רפואיות של מטופלים, ללא עירוב המטופלים.
"ניסוי רפואי / מחקר רפואי / ניסוי קליני"
ניסוי רפואי בבני-אדם, כמוגדר בתקנות ובאמנת הלסינקי. מטרותיו של מחקר רפואי בבני אדם, הן לשפר טיפול, אבחון ומניעה של מחלות, וכן לתרום להבנת האתיולוגיה והפתוגנזה של מחלות או מצבים רפואיים.
א- שימוש במוצר מחקר בניגוד לאישור שניתן לאותו שימוש לפי חיקוק, או כאשר השימוש האמור אינו מקובל בישראל לצרכים שמבוקש לייעדו להם, או שטרם נוסה בישראל, ויש בו או שמייעדים אותו להשפיע על בריאותו, גופו או נפשו של אדם או של עובר, או חלק מהם, לרבות המערך הגנטי.
ב- ביצוע כל הליך, פעולה או בדיקה בבן אדם, שאינם מקובלים - שאינם נהוגים בפרקטיקה הרפואית או המקצועית.
"ניסוי רפואי לא התערבותי"
מחקר בו, במהלך טיפול הניתן למשתתף בניסוי, נאספים נתונים על הטיפול ותוצאותיו, ובלבד שהטיפול מקובל למצבו של המשתתף בניסוי וניתן לו לפי החלטת מטפל, בלא שתוכנית הניסוי משנה את הטיפול המקובל או את המעקב אחר מצבו של המטופל, או משפיעה עליהם
"ניסוי רפואי ללא מוצר מחקר" - ניסוי רפואי הכרוך בפרוצדורה חדשה )שאינה נהוגה בפרקטיקה הרפואית או המקצועית ואינה כרוכה בשימוש במוצר מחקר( או בלקיחת דם ו/או דגימות ביולוגיות או במאגרי דגימות ביולוגיות או בשאלונים או ניסוי רפואי לא התערבותי ועוד.
הצהרת הלסינקי – תקציר
הצהרת הלסינקי היא מסמך הכולל מערכת של עקרונות אתיים, שמטרתם להנחות ביצוע מחקרים רפואיים הכוללים ניסוי קליני בבני אדם כך שיעמדו בסטנדרטים של אתיקה רפואית.
עקרונות ההצהרה הותוו בעצרת ההסדתרות הרפואית העולמית ה -18 שהתכנסה בהלסינקי בירת פינלנד בשנת 1964.
היסטוריה בקצרה:
משפט הרופאים שהתקיים במסגרת משפטי נירנברג, ובו הועמדו לדין רופאים נאצים על ביצוע ניסויים רפואיים בבני אדם בתקופת השואה, הסב את תשומת לבה של הקהילה הרפואית והמשפטית בעולם להיעדרם של תקינה, הנחיה וקוד אתי מוגדר בנושא. השופטים בנירנברג מצאו עצמם שופטים את הנאשמים שלא על סמך חוק ברור שהופר, כי אם על הפרת "העקרונות של חוקי האומות כפי שהם מתבטאים מההתנהגות המקובלת בין אנשים מתורבתים, מחוקי האנושיות ומצווי המצפון הציבורי". ממשפט הרופאים בנירנברג נגזר קוד אתי מחמיר שנודע כקוד נירנברג, והיה ניסיון מוצלח ראשון לגיבוש עקרונות אתיים שינחו מחקר רפואי הכולל ניסויים בבני אדם. עד 1964 היה זה הקוד המוגדר היחיד שהתייחס לניסויים בבני אדם, והוא נחשב כמקובל בקרב רופאים בעולם. בעקבות זאת היה צורך בהגדרות יותר מדוייקות ואלו הותוו כאמור בעצרת ההסתדרות הרפואית העולמית ה – 18 שהתכנסה בהלסינקי בירת פינלנד בשנת 1964.
עקרונות עיקריים:
כיבוד אוטונומיה: כל אדם זכאי להחליט אם להשתתף במחקר.
שקיפות והסכמה מדעת: החוקרים חייבים להסביר למטופל את מטרות המחקר, הסיכונים, והזכויות.
שיקול מוסרי קודם לשיקול מדעי: טובת הנבדק/משתתף המחקר קודמת תמיד.
תקנות משרד הבריאות נגזרות מהצהרה זו ואנחנו פועלים בהתאם לתקנות אלו.
מובילים ברפואה – עם יחס אישי
המרכז הרפואי שמיר (אסף הרופא) הוא אחד מבתי החולים הציבוריים הגדולים בישראל אך במקביל שומר על אווירה אישית, גישה אנושית, וליווי צמוד לכל משתתף במחקר. המטופלים שלנו אינם "עוד מספר בגיליון" – אלא שותפים אמיתיים למחקר ולקידמה רפואית.
מגוון מחקרים קליניים – בחתך אוכלוסייה אמיתי:
שמיר משרת אוכלוסייה מגוונת דתית, חילונית, צעירה, מבוגרת.
חוקרים ורופאים מהשורה הראשונה:
המחקרים אצלנו מנוהלים על ידי רופאים בכירים מהשורה הראשונה, בעלי ניסיון קליני ואקדמי רב, שחלקם מובילים מחקרים בינלאומיים בשיתוף אוניברסיטאות וחברות תרופות גלובאליות.
קשר הדוק בין משתתף המחקר לרופא החוקר:
הרופא החוקר האו לעיתים גם הרופא המטפל. זמינות גבוהה למענה, הסבר ושאלות במהלך המחקר.
נגישות ונוחות:
המרכז הרפואי שמיר (אסף הרופא) נמצא במיקום נגיש ומרכזי – קרוב לתחבורה ציבורית, חניה זמינה, וסביבה נעימה למטופלים ומשפחותיהם.
יעדי וועדת הלסינקי – המרכז הרפואי שמיר (אסף הרופא)
וועדת הלסינקי בשמיר מהווה את הזרוע האדמיניסטריבית, המקצועית והרגולטורית לניהול ותמיכה בכל פעילות המחקר הקליני המתקיימת בבית החולים.
הוועדה פועלת על פי סטנדרטים בינלואמייים ומשרד הבריאות, ותפקידה להבטיח מחקר איכותי, אתי, ובטוח – למטופלים וחוקרים כאחד.
היעדים המרכזיים:
- תמיכה וליווי מקצועי בחוקרים:
- ליווי חוקרים בכל שלבי המחקר, מהגשת הפרוטוקול ועד לסגירת המחקר.
- ייעוץ בנושאים רגולטוריים, אתיים ומדעיים.
- תמיכה בכתיבה, תכנון, וניהול תקציבי מחקר.
- הבטחת עמידה בדרישות רגולוציה ותקנות:
עבודה על פי כללי GCP.
וידוא עמידה בהנחיות משרד הבריאות, הצהרת הלסינקי וחקיקיה בינלאומית.
תיאום מול גורמי רגולציה חיצוניים.
- הנגשת מחקרים למטופלים:
- קידום תרבות של מחקר נגיש ושקוף לציבור.
- עידוד השתתפות מטופלים במחקרים באמצעות הסברה ברורה ובטוחה.
- שמירת על זכויות, סודיות, ובחירה חופשית של כל משתתף.
- קידום מצוינות אקדמית ורפואית:
- חיזוק הקשר בין רפואה אקדמית לעשייה קלינית.
- עידוד יוזמות מחקר בתוך הצוותים הרפואיים.
- פיתוח שיתופי פעולה עם אוניברסיטאות, חברות פארמה, וגופי מחקר ישראל ובעולם.
- מעקב בקרה ודיווח:
- ניטור שוטף של מהלך המחקרים ועמידה בתנאים המאושרים.
- ניתוח תקלות ודיווח לאירועים חריגים.
- שמירה על איכות ובטיחות לאורך כל חיי המחקר.
- חינוך והדרכת צוותים רפואיים:
- הכשרות והדרכות בנושא אתיקה, GCP, וניהול מחקר קליני.
מחקרים פתוחים במרכז הרפואי שמיר
הרכב וועדת הלסינקי
פרופ' ברקוביץ מתיתיהו, יו"ר הוועדה ומנהל היחידה לפרמקולוגיה קלינית.
פרופ' פיינסטון אהרן, סגן ומ"מ יו"ר הוועדה, מומחה בכירורגיה אורטופדית.
פרופ' טל אורנה, סגנית מנהל המרכז הרפואי.
הרב אייזק פיני, נציג ציבור.
ד"ר דגן דודו, מנהל יחידת ניהול סיכונים.
פרופ' קוצר ערן, מנהל מלר"ד ילדים.
פרופ' פוקס בנימין, מנהל מכון למחלות ריאה ותפקודי ריאה.
פרופ' אילן יונגסטר, מנהל יחידה למחלות זיהומיות – ילדים.
פרופ' שירין חיים, מנהל מכון גסטרואנטרולוגיה ומחלות כבד.
פרופ' בסן חיים, מנהל מכון התפתחות הילד ומערך נוירולוגיה ילדים.
פרופ' מימון רון, מנהל מכון לאולטרסאונד מילדותי.
פרופ' אנטר אלעד, מנהל מכון להפרעות קצב.
פרופ' ירוחימוב איגור, מנהל יחידת טראומה.
פרופ' בברשווילי איליה, מנהל יחידת נפרולוגיה.
פרופ' סמרוז'יק נועם, מנהלת היחידה לאנדוסקופיה גניקולוגית.
ד"ר שילוח אלי, מנהל מחלקת פנימית ה' לשעבר.
ד"ר כהן אלקנה ,PH.D
ד"ר קורן רונית, מנהלת מחלקה פנימית א'.
ד"ר גוטווין אודית, רופאה בכירה במערך ההמטולוגי.
ד"ר אטינג אווה, מנהלת מרפאת רשתית (עיניים).
ד"ר פיטרו קובי, רופא בכיר מחלקת אא"ג.
ד"ר פלוטניקוב גלינה, מנהלת יחידה להערכה גריאטרית.
ד"ר ניסימוב שגיא, רופא מומחה במחלקה לטיפול מייוחד ביילוד (פגייה).
ד"ר פאר ויקטוריה, מנהלת מעבדת בנק הדם.
ד"ר עינם רחמים, מנהל בנק הדם.
ד"ר בכור יאיר ,PH.D
ד"ר אלקן מתן, רופא בכיר פנימית א'.
ד"ר הרשקוביץ יהודה, רופא בכיר כירורגיה כללית.
מג'ר טולדנו מיכל, סגנית מנהלת בית המרקחת.
מג'ר אלקבץ יניב, רוקח.
מג'ר לודמן אהרון, אח.
עו"ד רם אושפיז, שובל יועץ משפטי, ממונה על חופש המידע והגנת הפרטיות. יו"ר ועדת בקרת מחקרים רפואיים ומכנס המלצות הוועדה להתקשרויות מסחריות.
עו"ד ארבל ליאור, ממונה על הסכמי מחקרים רפואיים.
מר שפיגל פיטר, ממונה על הסכמי מחקרים רפואיים.